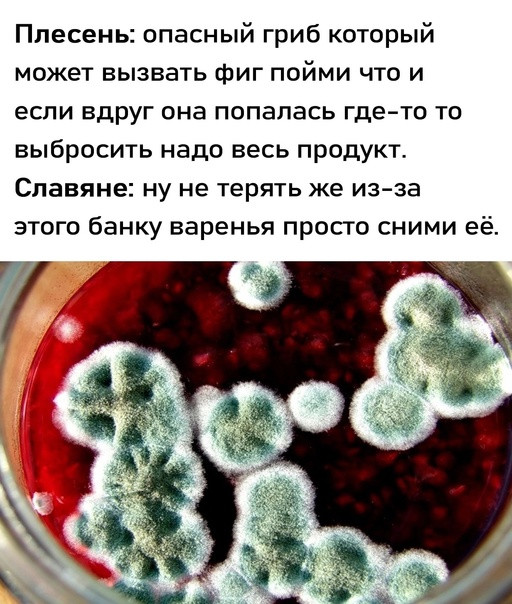

2 годы назад
2 годы назад
Если я сама тебе напишу ты обещаешь со мной пойти на встречу, пройти прогуляться или просто выпить кофе а там уже как получиться?
2 годы назад
2 годы назад
2 годы назад
Роскачество обнаружило в продаваемых в России пельменях патогенные бактерии!
Сообщается, что в продукции "Вкусвилл" выявлены листерии, а в пельменях "Горячая штучка", "Мясной дворик", "Сибирская коллекция", "Рестория" и "Тураково" — сальмонеллы.
Приятного аппетита!
Сообщается, что в продукции "Вкусвилл" выявлены листерии, а в пельменях "Горячая штучка", "Мясной дворик", "Сибирская коллекция", "Рестория" и "Тураково" — сальмонеллы.
Приятного аппетита!
Показать больше
2 годы назад
Премиальный подарок мужчине!
Шахматы и нарды с именной гравировкой из массива березы, меди и натуральной кожи.
Посмотреть цены: http://vk.me/vaso_chees?re...
Шахматы и нарды с именной гравировкой из массива березы, меди и натуральной кожи.
Посмотреть цены: http://vk.me/vaso_chees?re...
Показать больше
2 годы назад
17-летний Егор Балазейкин из Санкт-Петербурга получил 6 лет колонии за попытку поджога двух военкоматов!
Напомним, что он кинул коктейль Молотова в военкомат на Новочеркасской, а через неделю повторил действие в Кировске.
Его действия были квалифицированы, как терроризм.
Напомним, что он кинул коктейль Молотова в военкомат на Новочеркасской, а через неделю повторил действие в Кировске.
Его действия были квалифицированы, как терроризм.
Показать больше
При финансовой поддержке
Memes Admin
4 мс. назад